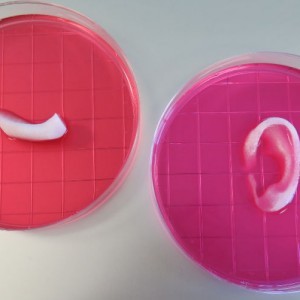

Θα μπορούσε κάποιος να επιζήσει σε μία μαύρη τρύπα;
Θα μπορούσε κάποιος να επιζήσει σε μία μαύρη τρύπα;
«Η ταχύτητα μπορεί να γίνει πιο παράξενη ακόμα και από την φαντασία. Αυτό αποδεικνύεται περίτρανα και σε ότι έχει να κάνει με τις μαύρες τρύπες» έχει δηλώσει στο παρελθόν ο καθηγητής Στίβεν Χόκινγκ, που έχει ασχοληθεί ιδιαιτέρως με το συγκεκριμένο ζήτημα τα τελευταία χρόνια. Η αλήθεια είναι ότι το να παγιδευτείς σε μαύρη τρύπα είναι εξαιρετικά απίθανο και μπορεί να συμβεί μόνο σε μία απίθανη περίπτωση στο μέλλον. Η απορία όμως του τι συμβαίνει στο εσωτερικό μιας μαύρης τρύπας κινεί το ενδιαφέρον εκατομμυρίων ανθρώπων.
Σίγουρα αν ρωτήσεις κάποιον τι παθαίνει ένας έμβιος οργανισμός που πέφτει σε μία μαύρη τρύπα, η πλέον δημοφιλής απάντηση θα ήταν ότι εξαϋλώνεται ή χωρίζεται σε κομμάτια. Η πραγματικότητα όμως είναι πιο παράξενη. «Από τη στιγμή που θα μπεις σε μία μαύρη τρύπα η πραγματικότητα θα χωριστεί στα δύο» σημειώνει ο Χόκινγκ και προσθέτει: «Στην πρώτη αυτομάτως θα αποτεφρωθείς ενώ στην δεύτερη θα βυθιστείς στην τρύπα απολύτως αλώβητος».
Σε μία πρόσφατη ομιλία του μάλιστα ο καθηγητής προσπάθησε να προχωρήσει την επιστημονική σκέψη που μελετά τις μαύρες τρύπες ένα βήμα πιο πέρα. Υποστήριξε ότι αν κάποιος βυθιστεί σε μία μαύρη τρύπα, υπάρχει η πιθανότητα να δραπετεύσει. «Με μεγάλη μου έκπληξη ανακάλυψα ότι μία μαύρη τρύπα μπορεί να αποβάλλει σωματίδια σε σταθερό ρυθμό» δήλωσε στην ομιλία του ο καθηγητής.

Θα είχε ενδιαφέρον να φανταστούμε ότι βλέπουμε κάποιον να μπαίνει σε μία μαύρη τρύπα. Αρχικά, όπως αναφέρει σε άρθρο του το bbc θα τον βλέπαμε να κινείται όλο και πιο αργά, σαν σε αργή κίνηση. Κάποια στιγμή θα τον βλέπαμε να «παγώνει», σαν κάποιος να έχει πατήσει «παύση». Λίγο πριν το υποθετικό άτομο βυθιστεί στο σκοτάδι, θα μετατραπεί σε στάχτη. Ας ξεχάσουμε όμως το υποθετικό άτομο και ας μπούμε εμείς στην θέση αυτού που τον καταπίνει η μαύρη τρύπα. Σε αυτήν την περίπτωση, κάτι πιο παράξενο συμβαίνει.
Σε περίπτωση που η μαύρη τρύπα είναι μικρή, η βαρύτητα θα ήταν μεγαλύτερη και γρήγορα θα μας τέντωνε μέχρι να μας σκοτώσει. Στην περίπτωση όμως που η μαύρη τρύπα είναι αρκετά μεγάλη, θεωρητικά, θα μπορούσαμε να ζήσαμε εκεί, πέφτοντας σε ελεύθερη πτώση, μέχρι να πεθάνουμε από άλλα αίτια.

Οι μαύρες τρύπες είναι εξ’ ορισμού ένα μέρος όπου οι κανόνες της φυσικής όπως τους γνωρίζουμε, καταρρέουν. Ο Αϊνστάιν μάλιστα υποστήριζε ότι όταν τα βαρυτικά κύματα αλλάζουν (όπως γίνεται στις μαύρες τρύπες), το ίδιο το σύμπαν καμπυλώνεται. Καθώς πηγαίνεις όλο και πιο μέσα σε μία μαύρη τρύπα, το σύμπαν γίνεται όλο και περισσότερο καμπυλωτό, μέχρι το κέντρο της τρύπας όπου το σύμπαν μετατρέπεται σε απόλυτη καμπύλη. Αυτό αποτελεί κάτι μοναδικό, ο χώρος και ο χρόνος μετατρέπονται σε απλά άχρηστα ανθρώπινα εργαλεία και κανένας γνωστός νόμος της φυσικής δεν έχει εφαρμογή.
Τι συμβαίνει σε αυτό το σημείο, κανείς δεν ξέρει. Ισως ένα παράλληλο σύμπαν, ένα πέρασμα στο παρελθόν ή το πίσω μέρος μιας βιβλιοθήκης (όπως στην ταινία Interstellar του 2014).
Ακολουθήστε το Protagon στο Google News